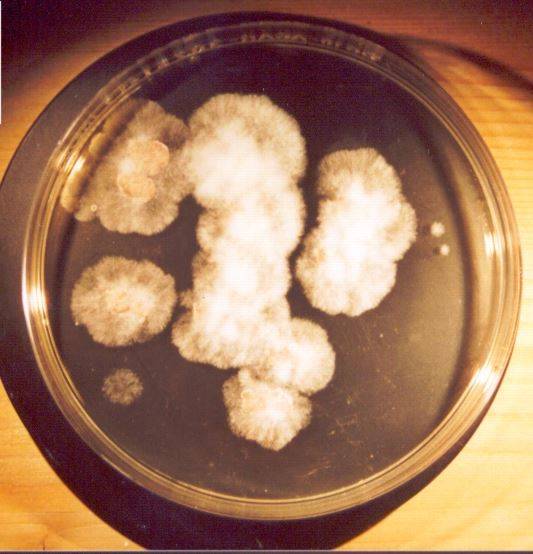

Wir können helfen
Untersuchung von Wohnungs- und Bauwerksschäden – Ermittlung von Schadensursachen
Feuchte, Schimmel, Zugluft
Schadstoffe (Wohngifte, Asbest), Elektrosmog, Radioaktivität
Lärm, Akustik, Erschütterungen
und viele andere Gebäudeprobleme
Das Leben spielt sich innerhalb eigener vier Wände ab. In Deutschland gibt es 19 Millionen Wohngebäude, 18 Millionen Büroarbeitsplätze und etwa 500.000 Bildungs- und Freizeiteinrichtungen.
Bedenklich ist, wenn Sie sich in Ihrer eigenen Wohnung, bei der Ausbildung oder der Arbeit nicht mehr wohlfühlen können. Es ist feucht, riecht müffelig, es ist zu warm oder zu kalt, der Wind pfeift durch die Fenster, Feuchteflecken werden sichtbar und es schimmelt. Das Unwohlsein kann auch von Ausdünstungen, elektromagnetischer oder radioaktiver Belastung oder Lärm ausgehen. Was tun? Sind die Wohnung, der Arbeitsplatz, der gebaute Lebensraum noch sicher? Was ist die Ursache? Wer ist Verursacher? Wie kann Abhilfe geschaffen werden? Das Internet bietet Millionen Hinweise, aber was trifft wirklich zu? Hier ist Expertenwissen gefragt.